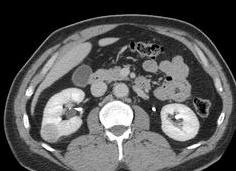
Гиперваскулярное образование почки что это такое Гиперваскулярное образование почки что это такое

Гиперваскулярное образование на почке: что это, виды и лечение
На почках, как и на других органах могут появляться новообразования. Доброкачественные отличаются тем, что не склонны к метастазированию и не вызывают сбои в работе почек.
Во время диагностики очень важно определить природу опухоли, чтобы назначить соответствующее лечение. Одним из признаков злокачественного новообразования является большое количество сосудов, находящихся рядом с опухолью. Такое новообразование называется гиперваскулярным.
Причины появления
Появлению такого образования способствуют провоцирующие факторы. Самыми распространенными являются:
- Отягощенная наследственность.
- Врожденные патологии почек.
-
Последствия инфекционного процесса.
- Большое количество воспалительных заболеваний.
- Травмы почек.
- Вредные привычки.
- Ожирение.
- Гемодиализ.
- Гормональные нарушения у женщин после 45 лет.
Если опухоль появилась на правой почке, то при росте она передавит нижнюю полую вену. В дальнейшем это может привести к тромбоэмболии легочной артерии. При объемном образовании на левой почке нарушается венозный кровоток.
Механизм развития
Рак развивается под воздействием вышеперечисленных факторов. В эпителии возникает перерождение. Эпителиальная клетка приобретает другую структуру. По истечению времени она не отмирает, а наоборот, начинает стремительно расти.
Некоторые клетки отрываются и с кровотоком присоединяются к другим органам. На них они также разрастаются и это называется метастазированием. Такой процесс происходит в течении всего лишь нескольких месяцев.
Разновидности
Если диагностировано гиперваскулярное образование на почке, то следует для начала разобраться в разновидностях, чтобы понять что это такое.
- Аваскулярная опухоль – это доброкачественное ограниченное образование.
- Гиповаскулярная опухоль – окружена малым количеством сосудов и редко прорастает в них. Чаще имеет доброкачественный характер, но есть маленькая вероятность появления злокачественной опухоли.
- Гиперваскулярная опухоль – окружена большим количеством сосудов и прорастает в них. Такие образования имеют только злокачественный характер.
Классификация
Классификация довольно большая и сложная. Однако создан более упрощенный вариант.
Рак лоханки
Самое частое новообразование. Сначала протекает без симптомов. По мере увеличения опухоли проявляется соответствующая симптоматика. Начальным проявлением является небольшое поднятие температуры тела, которая продолжается долгое время. Затем присоединяются другие симптомы, говорящие о наличии злокачественной опухоли.
Гипернефрома
Является самой опасной из опухолей. Локализуется в ткани нефрона. При диагностике нужно проводить гистологическое исследование. Является гиперваскулярным образованием, так как окружено множеством сосудов.
Гипернефрома
Саркома почки
Образование опасно для жизни и поражает преимущественно почки детей. Если саркома обнаружена на одной почке, то в скором времени возникнет и на второй. При такой опухоли метастазы довольно быстро поражают другие органы. Частичная резекция органа способствует ускорению разрастания раковых клеток. Поэтому, при наличии саркоме показано полное удаление органа.
Саркома почки
Клиническая картина
Пока опухоль малых размеров, то она может не проявлять себя. Однако с ее увеличением могут возникать симптомы, которые указывают на злокачественный характер новообразования:
- Снижение массы тела при полноценном питании.
- Интоксикация, характеризующаяся необоснованной слабостью и упадком сил.
- Гематурия неизвестной природы.
- Лихорадка.
- Бледность кожных покровов.
- Артериальная гипертензия.
- Отеки ног.
- Увеличение лимфатических узлов.
- Боли в пояснице.
Данные симптомы наблюдаются при значительном размере опухоли. Главной проблемой является не сама опухоль, а ее метастазирование, которое вызывает проблемы в работе других органов.
Иногда опухоль маскируется под другие заболевания. При давлении на другие органы может происходить симуляция симптомов.
Важно знать, что при макрогематурии без почечных колик следует провести обследование на предмет злокачественных опухолей.
Методы диагностики
Если наблюдаются симптомы, говорящие о возможном наличии злокачественной опухоли, то следует обратиться к врачу. Сначала врач проводит общий осмотр пациента и пальпацию. Иногда опухоль больших размеров можно обнаружить с помощью пальпации. Далее проводится ряд инструментальных и лабораторных исследований, в которые входят:
- Общий и биохимический анализ мочи.
- Общий и биохимический анализ крови.
- Онкологические маркеры.
- УЗИ почек.
- КТ и МРТ.
- Рентген с контрастным веществом.
- Уретроскопия.
- Цистоскопия.
Лечение
Лечение рака – это довольно тяжелая задача. В схему лечения включены хирургический, химиотерапевтический и радиологический методы. В основном сначала проводится операция, а затем применяется химиотерапия. Некоторые проводят облучение рентгеновскими лучами несмотря на то, что давно доказано о неэффективности данного метода.
Операции проводятся малоинвазивными методами: абляцией и криоабляцией. Перед операцией необходимо точно выяснить, какое количество тканей задействовано в процессе. Такая операция позволяет удалить опухоль, но при этом сохранить все функции органа. Однако она эффективна только на 1 и 2 стадии. На 3 и 4 стадии требуется полное удаление органа.
Химиотерапия показывает достаточно высокую эффективность, но при этом имеет множество побочных эффектов. Даже если опухоль перестала расти при проведении химиотерапии, не нужно останавливаться, а нужно довести курс до конца.
Таргетная терапия
В данном методе используются определенные препараты, которые влияют на состояние сосудов, снабжающих опухоль кровью. При недостаточном кровоснабжении опухоль отмирает. На данный момент такая терапия является наиболее успешной. По статистике, люди, получившие такую терапию живут дольше, чем те, кто лучился привычными методами.
Прогноз
При обнаружении рака 1 или 2 стадии, выживаемость пациентов в течение 5 лет составляет 90%. При обнаружении 3 или 4 стадии, прогноз неблагоприятный. Обычно, такие люди умирают в течение одного года после проведения лечения.
Таким образом гиперваскулярные новообразования на почках довольно опасны. При появлении симптомов следует обратиться к специалисту, иначе в дальнейшем это приведет к летальному исходу.
Гиперваскулярное образование почки: что это такое
Почки так же, как и другие органы, подвержены возникновению различных новообразований. Опухоли бывают доброкачественные и злокачественные. Первые отличаются тем, что не дают метастазов и не прорастают в соседние ткани и органы. Доброкачественные опухоли очень редко вызывают сбои в работе почек. Очень важно правильно диагностировать и классифицировать почечное новообразование, чтобы выбрать дальнейшую тактику лечения. Одним из признаков злокачественной природы опухоли является наличие множества кровеносных сосудов, оплетающих её. Такие новообразования относятся к категории гиперваскулярных.
Особенности и причины
Почки так же, как и другие органы, подвержены возникновению различных новообразований
Появление объёмного новообразования на почке вызывает совокупность провоцирующих факторов. Вот некоторые из них:
- наследственная предрасположенность;
- врождённые патологии развития органов;
- следствие инфекционного процесса в организме;
- высокая частота заболеваний воспалительного характера;
- осложнения после травмы.
Все объёмные почечные образования можно разделить на доброкачественные и злокачественные. Именно поэтому при обнаружении подобной патологии почек очень важно уточнить природу опухоли. Не менее важно знать, в какой из почек локализуется опухоль. Если новообразование в правой почке будет расти, то оно начнёт передавливать нижнюю полую вену. Это будет приводить к нарушению кровотока и повышению вероятности возникновения тромбоэмболии лёгочной артерии.
Если новообразование будет выявлено в левой почке, то в процессе его роста может ухудшаться венозный кровоток. Это будет приводить к расширению паховых вен и последующему отёку нижних конечностей.
Разновидности
В зависимости от характера кровоснабжения опухоли можно выделить их виды
Если у вас диагностировали гиперваскулярное образование почки, что это такое вы сможете понять, если разберётесь в классификации опухолей и их разновидностях. Так, в зависимости от характера кровоснабжения опухоли можно выделить следующие их виды:
Читайте также: Надпочечники при беременности
Злокачественные новообразования
Признак злокачественного образования — интоксикационный синдром, который проявляется в упадке сил и немотивированной слабости
Причин, по которым развивается почечно-клеточный рак, описываются в различных источниках обобщённо. К ним часто относят:
- различные неблагоприятные внешние факторы;
- изменения в организме, которые связаны с внутренними патологиями;
- генетическую предрасположенность;
- сбои в работе иммунной системы.
Есть ряд признаков, по которым можно заподозрить, что новообразование в почке имеет злокачественную природу. Среди них можно перечислить следующие:
- резкая потеря веса при полноценном питании;
- интоксикационный синдром, который проявляется в упадке сил и немотивированной слабости;
- гематурия, причину которой невозможно выяснить;
- лихорадочное состояние;
- гипертензия злокачественного характера;
- отёки ног;
- увеличенные лимфатические узлы;
- на поздних стадиях развития опухоли появляются боли.
Перечисленные клинические признаки злокачественных опухолей более характерны для поздних стадий их развития, когда размеры новообразования значительные. Пока опухоль небольшая, никаких клинических проявлений может не быть, то есть течение заболевания бессимптомное.
Наибольшая проблема злокачественных опухолей – это их склонность к метастазированию. Порой метастазы в другие органы намного быстрее сигнализируют о развитии злокачественного процесса, чем сама опухоль, локализующаяся на почке.
Внимание: если у больного наблюдается макрогематурия без симптомов почечной колики, то его срочно необходимо обследовать на предмет злокачественных почечных новообразований.
Диагностика
Если обнаружена макрогематурия или другие признаки злокачественного процесса, срочно проводится биохимический и клинический анализ крови
Если обнаружена макрогематурия или другие признаки злокачественного процесса, срочно проводится детальное обследование органа. При этом используются инструментальные и лабораторные методики:
- Общий клинический и биохимический анализ урины.
- Биохимический и клинический анализ крови.
- Обязательно используют онкологические маркеры.
- Ультразвуковое исследование почек.
- КТ и МРТ.
- Радиоизотопная рентгенография.
- Уретроскопия.
- Цистоскопия.
Проявления злокачественных опухолей почки
Чаще всего встречающееся злокачественное новообразование почек – это рак лоханки
Если говорить о гиперваскулярных образованиях почки, то их классификация довольно обширная и сложная. Мы рассмотрим более простую и понятную для всех классификацию, согласно которой злокачественные почечные опухоли делят на следующие виды:
- расстройство мочеиспускания;
- в моче присутствует кровь;
- боли могут быть очень сильными, а порой просто нестерпимыми;
- потеря аппетита;
- общее истощение организма;
- нарастающая интоксикация;
- из-за ослабления иммунитета дают о себе знать те органы, в которых уже есть метастазы.
Важно: главная опасность гипернефромы кроется в том, что она длительное время не проявляется никакими симптомами и диагностируется на поздней стадии, когда есть множественные метастазы.
В ходе лечения злокачественных новообразований почки используется не только хирургическое удаление части или всего поражённого органа, но и комплексное медикаментозное лечение, которое включает курс гамма-облучения и химиотерапии. Помните, чем раньше начато лечение злокачественного почечного образования, тем больше шансов сохранить жизнь больного.
Источник
Гиперваскулярное образование на почке: что это, виды и лечение
Причины появления
- Отягощенная наследственность.
- Врожденные патологии почек.
- Последствия инфекционного процесса.
- Большое количество воспалительных заболеваний.
- Травмы почек.
- Вредные привычки.
- Ожирение.
- Гемодиализ.
- Гормональные нарушения у женщин после 45 лет.
Механизм развития
Разновидности
Классификация
Рак лоханки
Гипернефрома
Саркома почки
Клиническая картина
- Снижение массы тела при полноценном питании.
- Интоксикация, характеризующаяся необоснованной слабостью и упадком сил.
- Гематурия неизвестной природы.
- Лихорадка.
- Бледность кожных покровов.
- Артериальная гипертензия.
- Отеки ног.
- Увеличение лимфатических узлов.
- Боли в пояснице.
Методы диагностики
Лечение
Таргетная терапия
Прогноз
(Пока оценок нет) Загрузка…
Гиперваскулярное образование почки: что это такое
Особенности и причины
Почки так же, как и другие органы, подвержены возникновению различных новообразований
- наследственная предрасположенность;
- врождённые патологии развития органов;
- следствие инфекционного процесса в организме;
- высокая частота заболеваний воспалительного характера;
- осложнения после травмы.
Разновидности
В зависимости от характера кровоснабжения опухоли можно выделить их виды
- Аваскулярная опухоль – это ограниченное изолированное образование доброкачественного происхождения.
- Гиповаскулярное новообразование окружено незначительным количеством сосудов и редко прорастает в них. Такие опухоли чаще всего доброкачественные, но существует небольшая вероятность их злокачественного перерождения.
- Гиперваскулярная опухоль окружена значительным количеством кровеносных сосудов и может прорастать в них. К этой категории относятся только злокачественные новообразования органа.
Злокачественные новообразования
Признак злокачественного образования — интоксикационный синдром, который проявляется в упадке сил и немотивированной слабости
- различные неблагоприятные внешние факторы;
- изменения в организме, которые связаны с внутренними патологиями;
- генетическую предрасположенность;
- сбои в работе иммунной системы.
- резкая потеря веса при полноценном питании;
- интоксикационный синдром, который проявляется в упадке сил и немотивированной слабости;
- гематурия, причину которой невозможно выяснить;
- лихорадочное состояние;
- гипертензия злокачественного характера;
- отёки ног;
- увеличенные лимфатические узлы;
- на поздних стадиях развития опухоли появляются боли.
Диагностика
Если обнаружена макрогематурия или другие признаки злокачественного процесса, срочно проводится биохимический и клинический анализ крови
- Общий клинический и биохимический анализ урины.
- Биохимический и клинический анализ крови.
- Обязательно используют онкологические маркеры.
- Ультразвуковое исследование почек.
- КТ и МРТ.
- Радиоизотопная рентгенография.
- Уретроскопия.
- Цистоскопия.
Проявления злокачественных опухолей почки
Чаще всего встречающееся злокачественное новообразование почек – это рак лоханки
- Рак лоханки. Чаще всего встречающееся злокачественное новообразование почек – это рак лоханки. Заболевание очень долгое время протекает без каких-либо симптомов. Однако по мере разрастания опухоли симптоматика становится более выраженной. Первым признаком заболевания является постоянная субфебрильная температура, после этого постепенно проявляются другие симптомы, характерные для злокачественного процесса. Больные отмечают такие признаки недуга:
- расстройство мочеиспускания;
- в моче присутствует кровь;
- боли могут быть очень сильными, а порой просто нестерпимыми;
- потеря аппетита;
- общее истощение организма;
- нарастающая интоксикация;
- из-за ослабления иммунитета дают о себе знать те органы, в которых уже есть метастазы.
- Гипернефрома проявляется так же, как и другие злокачественные новообразования. Чтобы отличить её от других опухолей, необходимо провести гистологическое исследование. Это злокачественное образование очень опасное. Оно локализуется на эпителии нефрона. При проведении исследования определяется как гиперваскулярное новообразование, поскольку окружено множеством кровеносных сосудов, в которые оно может прорастать, образуя кровоизлияния.
- Саркома почки – это быстро растущее образование, которое чаще всего поражает почки детей и очень опасно для жизни. В большинстве случаев, если опухоль была диагностирована на одной из почек, через некоторое время эта же патология поражает и вторую почку. Данное новообразование склонно к метастазам и очень быстро прорастает в другие органы. Если выполнять частичную резекцию органа, то злокачественные клетки начинают ещё быстрее разрастаться, поэтому при такой патологии показано полное удаление почки.